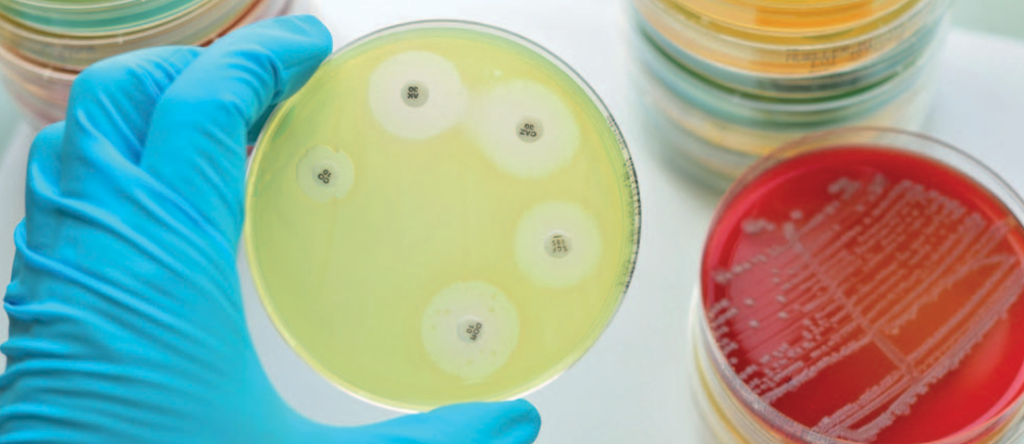

3L Industria: Innovación, compromiso y crecimiento

3L Industria se ha consolidado como una empresa referente en la fabricación de envases plásticos para la industria alimenticia, con un fuerte enfoque en el sector de la heladería.
Novonesis: Busca llevar los lácteos al siguiente nivel

El líder mundial en biosoluciones anuncia su ambición de ampliar aún más su colaboración con los clientes y reforzar su liderazgo en el mercado.
Primer Campeonato Nacional de Panes de Masa Madre

Siguiendo con la tendencia que se viene profundizando desde hace varios años, Publitec llevó adelante su convocatoria para elaboradores de pan con masa madre.
Significativo avance para la producción de caseína de origen microbiano

Investigadores desarrollaron dos tecnologías para lograr su fosforilación, con propiedades funcionales y nutricionales semejantes a la caseína bovina.
Estabilidad y vida útil de la matriz cárnica envasada al vacío. Principios y aplicaciones.

La calidad de la carne se puede determinar mediante cuatro parámetros relevantes: nutricional, sensorial, tecnológico y de seguridad.
Entrevista a Guillermo Ferrero: El Director Ejecutivo de CAFYPEL habla sobre los objetivos y logros de la institución

La Cámara Argentina de Fabricantes y Proveedores de Equipamientos, Insumos y Servicios para la Cadena Láctea (CAFyPEL) es una entidad gremial empresaria que hoy representa a 65 firmas.
Ionización Gamma. Una herramienta clave para la industria y el comercio internacional

Esta tecnología aporta valor en cada etapa del ciclo productivo y garantiza el cumplimiento de las normativas para el comercio global.
TodoLáctea 2025 en Esperanza: El que no se capacita es porque no quiere…

Así fue la última edición de TodoLáctea, la gran exposición lechera de la Argentina y el Cono Sur, que se desarrolló del 13 al 15 de mayo en la ciudad de Esperanza, Santa Fe, organizada por el Grupo TodoAgro.
Impactos sanitarios y económicos de la resistencia a los antimicrobianos en humanos y animales productores de alimentos
La serie EcoAMR (Impactos sanitarios y económicos de la resistencia a los antimicrobianos en humanos y animales productores de alimentos), utilizó los datos más recientes de 204 países y 621 localidades subnacionales para pronosticar el impacto de la resistencia a los antimicrobianos (RAM) en la mortalidad, los costos de atención médica, la seguridad alimentaria y la economía global.
Copa América del Helado Artesanal

Este certamen reunió ocho países, siete de América Latina más Estados Unidos. Fue organizado por AFADHYA, Publitec y la Federación de Pasteleros. Los equipos participantes fueron Argentina, Ecuador, Perú, México, Venezuela, Brasil, Colombia y Estados Unidos.
TUTTOFOOD al encuentro del mercado latinoamericano

Del 29 de septiembre al 1 de octubre de 2025, TUTTOFOOD estará presente en Espacio Food & Service, feria profesional de la industria alimentaria, que se llevará a cabo en Espacio Riesco, Huechuraba, Santiago de Chile.
SIMES Bombas lobulares con by-pass y válvula limitadora de presión

Simes S.A. es una empresa santafesina dedicada desde hace cinco décadas al diseño y fabricación de máquinas y equipos para las industrias procesadoras de alimentos.